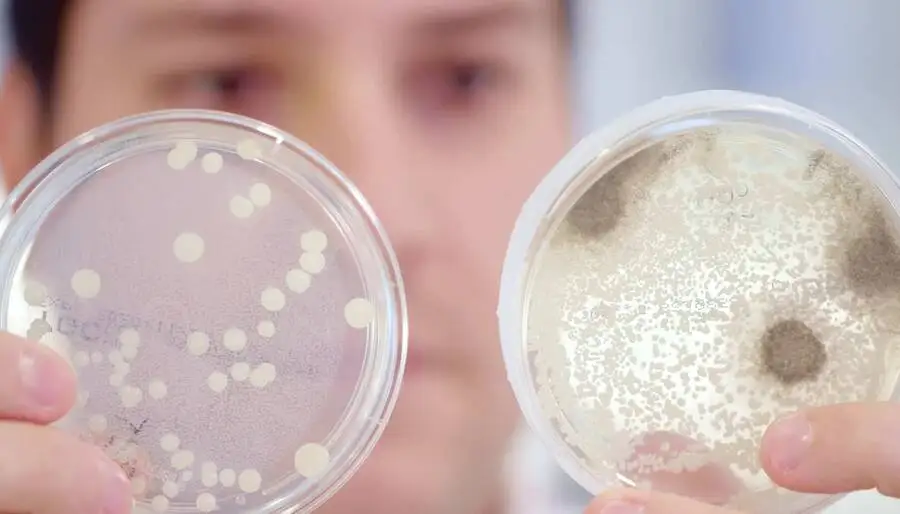

Чистый натуральный питательный активный сухой дрожжевой порошок пивной для свиней поросят
- Категории: Admixture & Additives >>>
- Поставщик: Qingdao,Yijiali,Agriculture,And,Animal,Husbandry,Development,Co.,Ltd.
Поделиться:
Описание и отзывы
Характеристики
Product Description


Brewer Yeast Powder for
Pig Nutrition
Yeast-based products for animal nutrition from Yegarlee Yeast provides efficient and sustainable products and solutions for pet nutrition, which aims to improve the quality and palatability of pig food, enhance the intestinal health, relieve stress and resist senescence.
With Yegarlee, you will get healthier and happier pet partners.





Application

Features & Advantages


As a global leader in animal nutrition, Yegarlee provides high-quality, sustainable nutrition for all your needs.
· 100% Pure Premium Natural Ingredients
· Adopt leading production technology
· Strictly control the production process
· Extra protein with growth-promoting factors
· Adopt leading production technology
· Strictly control the production process
· Extra protein with growth-promoting factors
· Provide unique nutritional solutions
· Sufficient inventory guarantee
· Fast worldwide delivery

Product Paramenters

Product Name | Beer Yeast Powder | |||||||
Raw Material | Crude protein ≥40.0% | Ash ≤ 10.0% | Moisture ≤ 10.0% | |||||
Package | 1kg/bag, 25kg/bag, 850kg/package | Storage | Storage | cool and dry place | ||||
Suggested addition amount | ||||||||
Ruminant Animal | Aquaculture | Pig | Poultry | Special Animal | ||||
3~10% | 2~10% | 2~10% | 2~10% | 2~10% | ||||

Details Images








Certifications


Why Choose Us


FAQ

Feel free to contact us with any questions!
1. Are you a manufacturer or trading company?
We are a manufacturer engaged in the application of biological industry for more than 20 years.
We are a manufacturer engaged in the application of biological industry for more than 20 years.
2. Does your factory have rich experience in exporting feed additives?
Our products have a broad overseas demand market and are exported to Vietnam, Japan, Korea, Malaysia, Australia, India, Germany, Philippines and other places.
Our products have a broad overseas demand market and are exported to Vietnam, Japan, Korea, Malaysia, Australia, India, Germany, Philippines and other places.
3. Can I get some samples for testing?
Yes, we can provide a small amount of free samples for your test if you can pay the freight or freight collect.
Yes, we can provide a small amount of free samples for your test if you can pay the freight or freight collect.
4. How to confirm the product quality before placing an order?
Quality first is our production tenet. Each batch of goods is strictly inspected before leaving the factory.
Quality first is our production tenet. Each batch of goods is strictly inspected before leaving the factory.
5. What is your delivery time?
We have stock anytime if there is quantity. For large quantities of goods, 1-7 days is enough.
We have stock anytime if there is quantity. For large quantities of goods, 1-7 days is enough.
6. Do you have professional after-sales service?
Our after-sales service team is online 7*24 hours.
Our after-sales service team is online 7*24 hours.

Похожие товары
Очистка пруда для кормления креветок
US $2.50-$3.50
Кокосовое масло для корма оптом
US $2.35-$2.75
Заводской поликарбоксилат на основе суперпластификатора по низкой цене
US $780.00-$950.00






















